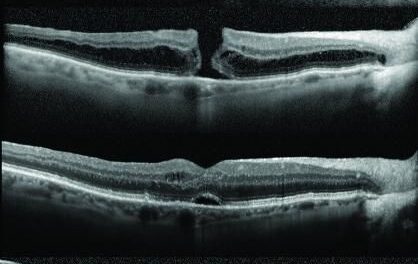
Agujero macular

La pintura y las patologías oculares
Podemos ver como las patologías oculares como la Degeneración Macular (DMAE) o la catarata puede afectar en arte pictórico, gran número de artistas padecieron patologías, como Edward Much (El grito), Monet (Los Nenúfares), Degas (El Café de Ambassadeurs).
Las cataratas hace que los colores se acerquen mas a azules y grises y la DMAE deforma las imágenes, por lo que muchas veces vemos como la pintura de estos artistas y muchos más evolucionan en función de su patología.
Tanto la reconstrucción del diagnóstico basado en la experiencia de los especialistas como la documentación histórica de las enfermedades de los artistas pueden ayudar a comprender la manera en que se presentó la realidad a estos pintores y cuáles fueron sus luchas y decepciones con la finalidad de poner el arte dentro de un contexto apropiado.